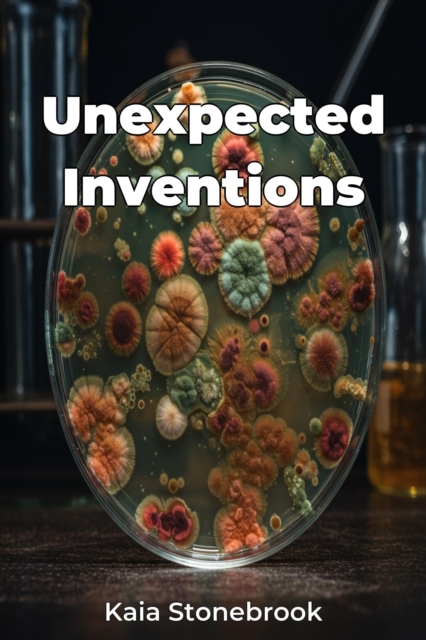
Unexpected Inventions

Unexpected Inventions
Unexpected Inventions explores the fascinating realm of accidental discoveries and their profound impact on science, technology, and history. This book sheds light on how serendipity and unintentional breakthroughs have shaped our world, revealing that many common items owe their existence to chance occurrences. For example, the book examines the story behind Silly Putty, a playful invention born ...
Unexpected Inventions explores the fascinating realm of accidental discoveries and their profound impact on science, technology, and history. This book sheds light on how serendipity and unintentional breakthroughs have shaped our world, revealing that many common items owe their existence to chance occurrences. For example, the book examines the story behind Silly Putty, a playful invention born ...
